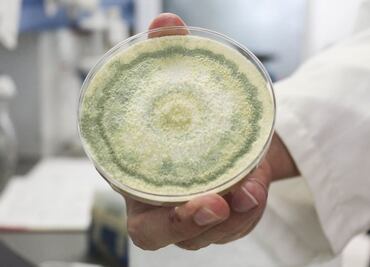
Enfermedades por hongos, amenaza en todo el mundo

El abuso de medicinas para el Covid-19, el calentamiento global, el comercio internacional y los viajes, por ejemplo, han contribuido al aumento y evolución de estos microorganismos cada vez más resistentes a los tratamientos. Especialistas advierten sobre la salud pública

Por qué los hongos no se lavan
Si quiere conservar su sabor y textura lo mejor es que no laves los hongos

OMS presenta lista de los hongos más peligrosos para los humanos; advierte falta de tratamientos
Las infecciones de estos hongos están aumentando en el mundo debido al cambio climático y el incremento de los viajes internacionales, con especial ascenso de las infecciones en hospitales

Con las lluvias, comenzó la temporada de este exquisito regalo de la madre naturaleza. Conoce algunos de los hongos que puedes encontrar en México y sus usos

Lánzate a la mixteca oaxaqueña y convive con la naturaleza, aprende de los hongos y dsifruta del festín gastronómico que nos tienen preparado

Los hongos son muy nutritivos y sabrosos, aprende a cultivarlos en casa con esta guía

Los chefs Alejandro Piñón de los Danzantes y Sergio Camacho de Corazón de Maguey nos dan la receta, prepárala en casa y compártela con tu familia y amigos

Las lluvias ya llegaron, y con ellas, el reino fungi está listo para ser el protagonista de nuestras mesas, conoce las ferias, degustaciones y menús dedicados a ellos

En este lugar podrás comer hongos de la entrada al postre. Hasta las bebidas tienen cabida para este ingrediente